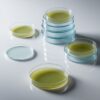

As a trusted provider of laboratory supplies. we deliver a wide range of high-quality consumables and equipment tailored to researchers and medical professionals. Our inventory includes micropipettes. multichannel pipettes. volumetric pipettes. repeater pipettes. and positive displacement pipettes from brands like Eppendorf. Sartorius. Integra. and Gilson. Accessories such as pipette tips. pipette fillers. and wide bore tips are readily available. Key lab items such as petri dishes. cryovials. cryoboxes. agar plates. and parafilm materials ensure proper sample handling. Additionally. we supply dropper bottles in glass. plastic. and amber varieties. Falcon tubes. tincture bottles. and Pasteur pipettes. Advanced tools like the Eppendorf Xplorer. Multipette. and Research Plus are also available. Trust us to provide the tools you need for reliable and precise laboratory operations.
dish petri
R55.00 Ex VAT
. We take pride in offering an extensive range of laboratory consumables and equipment to meet the exacting standards of researchers and healthcare professionals. Our collection includes micropipettes. multichannel pipettes. volumetric pipettes. and positive displacement pipettes. with brands like Sartorius. Eppendorf. Integra. and Rainin. Accessories like pipette tips. pipette fillers. and wide bore tips complete the selection. Key lab items such as petri dishes. cryovials. cryoboxes. agar plates. and parafilm tape are readily available. Additionally. we supply dropper bottles. Falcon tubes. tincture bottles. and Pasteur pipettes. Advanced tools like the Eppendorf Multipette. Research Plus. and Xplorer systems provide cutting-edge solutions for your lab. Rely on us for dependable laboratory supplies.